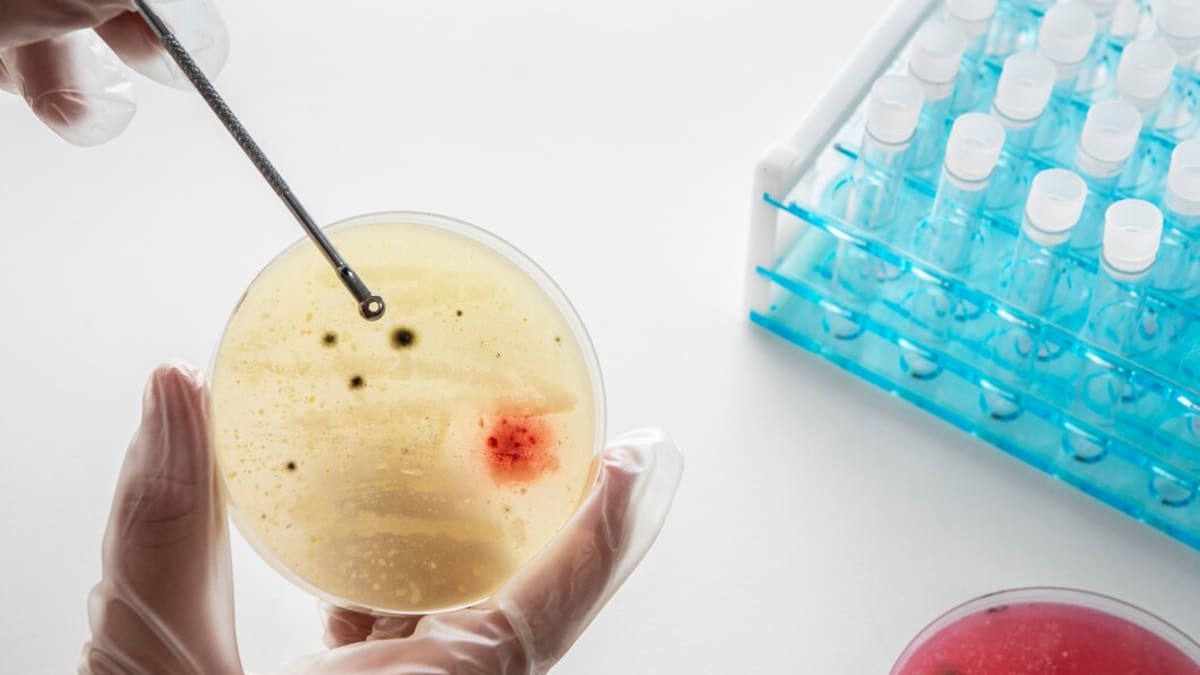

La resistencia a los antimicrobianos (RAM) es una crisis sanitaria mundial cuyas consecuencias no hemos dimensionado como deberíamos porque no solo compromete la efectividad de tratamientos médicos, sino también la salud animal, la producción de alimentos y el medioambiente.
Según la Organización de las Naciones Unidas para la Alimentación y la Agricultura (FAO), la RAM es causada por el uso indebido o excesivo de medicamentos para tratar y prevenir enfermedades en humanos y animales, especialmente en la ganadería, la agricultura y la producción acuícola.
Estimaciones publicadas en The Lancet prevén para los próximos años un aumento del 67,5 % de las muertes anuales atribuidas directamente a la RAM bacteriana, pasando de 1,14 millones en 2021 a 1,91 millones en 2050. Y las muertes asociadas con la RAM podrían casi duplicarse: de 4,71 millones en 2021 llegarían a 8,22 millones en 2050.
Para conocer el contexto local, la Universidad Simón Bolívar lideró una investigación en Barranquilla en la que se aplicó un instrumento con preguntas de conocimientos, actitudes y prácticas a 399 profesionales de medicina, enfermería, química y farmacia, microbiología, personal de vigilancia y control de infecciones y líderes de calidad de 15 instituciones entre hospitales y clínicas.
Conocimientos y prescripción
Los resultados, publicados en la revista especializada Heliyon, revelaron que la mayoría de encuestados tiene buenos conocimientos del uso de medicamentos y que deben fortalecerlos respecto a “cómo se disemina la resistencia a los antibióticos en el ambiente hospitalario y en la comunidad”, explica la médico epidemióloga Soraya Salcedo Mendoza, profesora e investigadora de la Facultad de Ciencias de la Salud y coordinadora del Grupo para el Estudio de la Resistencia Microbiana de Unisimón.
De acuerdo con el análisis, del 89,5 % al 98 % de los profesionales tenía un conocimiento considerable sobre el uso de antibióticos y la propagación de la resistencia a los antibióticos.
Los desafíos surgen al momento de prescribir o no medicación contra patógenos: por temor a que empeore el estado de los pacientes, un 42,9 % recetó al menos una vez durante la semana anterior a la encuesta, pese a considerarlo innecesario.
“Esto sugiere que el temor a complicaciones en los pacientes sigue promoviendo un uso intensivo de antibióticos, aunque muchos profesionales cuentan con conocimientos sólidos y acceso a guías”, plantea la investigación.
¿Qué se recomienda?
Los autores de la encuesta resaltan que muchos profesionales se sienten confiados y apoyados en su capacidad para prescribir y manejar antibióticos, pero se requieren estrategias que fomenten el acceso a las guías de manejo de infecciones y brindar asesoramiento del uso de antibióticos.
“Debemos controlar las barreras que dificultan la accesibilidad a las guías y los materiales necesarios para orientar prácticas apropiadas en el tratamiento de infecciones, y en la prevención y control de la RAM”, agrega la profesora Salcedo.
Es de anotar que la Semana Mundial de la Concientización sobre la RAM es conmemorada del 18 al 24 de noviembre por la Organización Mundial de la Salud (OMS) para que haya más comprensión de esta problemática mundial de salud pública.
La RAM y el cambio climático
En otros análisis se ha evidenciado que el cambio climático incide en el comportamiento de la RAM. El incremento de temperaturas en un mínimo de 10 grados produjo en los últimos 30 años que la resistencia antimicrobiana aumentara un 5 % en bacterias como E. Coli, Kleibsella pneumoniae y Estafilococo aureus.
“Hay emergencia y reemergencia de patógenos asociados al clima, lo que expresa que los climas extremos impactan enfermedades producidas por bacterias como E. Coli, Klebsiella pneumoniae y Estafilococo aureus, caracterizada como muy resistente”, complementa Wilmer Villamil Gómez, profesor Ph.D., investigador del Grupo de Enfermedades Infecciosas y Tropicales de Unisimón.
Y agregó: “ello nos motiva a hacer estudios relacionados con la RAM y la emergencia climática, para lo que venimos proponiendo la estrategia One Health”.